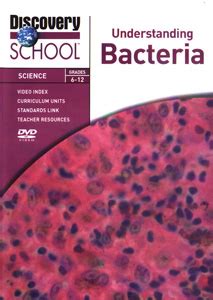

# lmzhBakteri: Your Guide to Understanding Bacteria
Hey guys! Ever wondered what exactly **lmzhBakteri** are, or maybe you've just heard the term floating around and are curious? Well, you've come to the right place! Today, we're diving deep into the fascinating world of bacteria, specifically focusing on understanding lmzhBakteri. We'll break down what they are, why they're important, and how they impact our lives, from the food we eat to the health of our planet. So, grab a snack (maybe one with some good bacteria in it!), and let's get started on this bacterial adventure!
## What Exactly Are lmzhBakteri?
So, let's get straight to it: **What are lmzhBakteri?** At its core, the term "lmzhBakteri" likely refers to a specific type or group of bacteria, or perhaps a classification that includes certain characteristics we'll explore. Without a universally recognized scientific term "lmzhBakteri," we can infer it might be a placeholder for bacteria with specific traits or a unique identifier within a particular context, like a research project or a specific ecosystem study. However, to give you the best understanding, let's talk about bacteria in general and then hypothesize what "lmzhBakteri" might represent. Bacteria are **single-celled microorganisms** that are found virtually everywhere on Earth – from the deepest oceans to the highest mountains, and yes, even inside and on our bodies! They are incredibly diverse, with countless species, each with its own unique properties and roles. Think of them as the original life forms on our planet, existing for billions of years. They come in various shapes, like spheres (cocci), rods (bacilli), and spirals (spirilla), and they reproduce rapidly, usually through a process called binary fission. Some bacteria are **beneficial**, playing crucial roles in ecosystems and human health, while others can be **pathogenic**, causing diseases. Understanding these differences is key to appreciating the vast impact of bacteria on our world. When we consider "lmzhBakteri," it's possible this term is used in a specific scientific paper, a lab experiment, or even a fictional context to denote bacteria that exhibit certain behaviors, genetic markers, or environmental adaptations. For instance, it could refer to bacteria isolated from a specific source (like soil from a particular region, hence the 'lmzh' possibly indicating a location or researcher), or bacteria engineered for a specific purpose in biotechnology. The 'Bakteri' part is clearly a nod to bacteria. The specificity of 'lmzh' is what makes it intriguing. It could be an abbreviation, a code, or a unique identifier. Regardless, our exploration will focus on the general characteristics and importance of bacteria, providing a framework for understanding what *any* specific group, including our hypothetical 'lmzhBakteri', might entail. We'll delve into their structure, how they thrive, and the incredible jobs they do – and sometimes, the trouble they cause. So, stick around as we unravel the mysteries of these tiny but mighty organisms!
## The Incredible World of Bacteria: More Than Just Germs
Alright, guys, let's shift gears and talk about the **incredible world of bacteria**. When most people hear the word "bacteria," their minds immediately jump to "germs" and "sickness." And sure, some bacteria *are* harmful and can make us quite sick. But honestly, that's just a tiny fraction of the story! The vast majority of bacteria are actually **harmless or even essential for life** as we know it. Think about it – these microscopic organisms have been around for billions of years, shaping our planet's ecosystems long before humans even showed up. They are the unsung heroes of countless natural processes. For example, bacteria in the soil are **vital decomposers**, breaking down dead organic matter and recycling nutrients, which is absolutely crucial for plant growth. Without them, our planet would be buried under layers of dead stuff! Then there are the bacteria in our own bodies, especially in our gut. This community, often called the **microbiome**, is incredibly complex and plays a massive role in our health. These friendly bacteria help us digest food, produce essential vitamins like Vitamin K and some B vitamins, and even train our immune systems to distinguish between friend and foe. Seriously, a healthy gut microbiome is linked to everything from better digestion to improved mood and a stronger immune defense. Imagine your gut as a bustling city, and the bacteria are the hardworking citizens keeping everything running smoothly. Now, let's consider what **lmzhBakteri** might represent in this context. If 'lmzh' denotes a specific characteristic, perhaps these bacteria are known for their exceptionally efficient decomposition abilities, making them key players in bioremediation efforts to clean up pollution. Or maybe they are particularly adept at producing a specific vitamin or compound beneficial to human health, making them targets for the food or pharmaceutical industries. The diversity of bacteria is mind-boggling. They can live in extreme environments, like hot springs or the frozen Antarctic ice, and some can even survive on unusual energy sources. This adaptability is one of their greatest strengths and explains why they are found absolutely everywhere. So, the next time you think about bacteria, try to remember that it's not just about the bad guys. There's a whole universe of tiny organisms out there doing amazing work, keeping our world spinning and our bodies functioning. It's a world that's definitely worth exploring!
### Bacteria in Our Ecosystems: The Unseen Force
Let's get real for a second, guys. The **role of bacteria in our ecosystems** is nothing short of profound. These microscopic powerhouses are the invisible architects of our planet, constantly at work, performing tasks that are absolutely fundamental to life. When we talk about ecosystems, we're usually thinking about the big stuff – the trees, the animals, the rivers. But beneath the surface, a relentless and essential microbial world, dominated by bacteria, is what keeps everything in balance. One of the most critical functions bacteria perform is **nutrient cycling**. Think about nitrogen, phosphorus, and carbon – these are essential elements for all life. Bacteria are the primary drivers behind converting these elements into forms that plants and other organisms can use. For instance, certain bacteria in the soil can take nitrogen gas from the atmosphere and "fix" it into ammonia, a form that plants can absorb through their roots. Without these nitrogen-fixing bacteria, plant life would be severely limited, and the entire food web would collapse. Similarly, other bacteria are responsible for decomposing dead organisms and waste products, returning vital nutrients back into the soil and water, making them available for new life. It's a perpetual cycle, and bacteria are the master recyclers. Another crucial role is in **water purification**. In natural water systems, bacteria help break down organic pollutants, preventing them from accumulating and harming aquatic life. Wastewater treatment plants heavily rely on specific bacterial communities to process sewage and make the water safe to return to the environment. So, when we consider **lmzhBakteri** in an ecological context, we might be looking at a specific strain identified for its exceptional ability to degrade a particular pollutant, or perhaps a bacterium that plays a unique role in a specific habitat, like a coral reef or a volcanic vent. Their ability to adapt and thrive in diverse environments is key to their ecological importance. Some bacteria are photosynthetic, contributing to oxygen production, similar to plants. Others form symbiotic relationships with larger organisms, providing benefits that help those organisms survive. For example, some marine invertebrates host specific bacteria that help them process food or detoxify their environment. The sheer diversity and metabolic capabilities of bacteria mean they can occupy almost every niche on Earth, influencing everything from global climate patterns to the health of individual organisms. They are the **unseen force** that sustains life, and understanding their complex interactions within ecosystems is crucial for conservation and environmental management.
### Bacteria and Human Health: Friends and Foes
Now, let's get personal, guys, and talk about **bacteria and human health**. This is where things can get a bit complicated, because bacteria are both our allies and, sometimes, our adversaries. On the one hand, we have the **pathogenic bacteria** – the ones that cause infections and diseases. Think *Streptococcus pyogenes* causing strep throat, or *Salmonella* causing food poisoning. These bacteria invade our bodies, multiply, and disrupt normal functions, leading to illness. Our immune systems are constantly on guard, fighting off these invaders, and we have developed incredible tools like antibiotics to combat them. However, it's crucial to remember that these are a minority of bacterial species. The vast majority of bacteria associated with humans are **commensal or mutualistic**, meaning they live with us without causing harm, and often provide significant benefits. The human microbiome, especially the gut microbiome, is a prime example. Billions upon billions of bacteria reside in our intestines, and they are essential for our well-being. They help us break down complex carbohydrates that our own enzymes can't handle, extract nutrients, and synthesize vital vitamins like K and B vitamins. They also play a critical role in developing and regulating our immune system, teaching it to tolerate harmless substances while mounting a defense against genuine threats. A healthy microbiome can protect us from colonization by harmful pathogens by competing for space and resources. When we talk about **lmzhBakteri** in relation to human health, it could refer to a specific bacterium being studied for its probiotic potential – meaning it could be beneficial when consumed, perhaps to restore gut balance after antibiotic use or to boost immune function. Conversely, it might be a newly identified pathogen that researchers are trying to understand to develop new treatments. The balance of our microbiome can be easily disrupted by factors like diet, stress, and antibiotic use. Restoring this balance is increasingly recognized as key to preventing and managing a wide range of health issues, from digestive disorders to allergies and even mental health conditions. So, while we must remain vigilant against harmful bacteria, it's equally important to appreciate and nurture the beneficial bacterial communities that are integral to our health and survival. They are our microscopic partners in a lifelong dance of health and resilience.
## The Future of Bacteria: Innovation and Challenges
So, what's next for bacteria, guys? The **future of bacteria** is incredibly exciting, filled with potential for innovation and also presenting some significant challenges we need to tackle head-on. On the innovation front, bacteria are becoming increasingly important in biotechnology and medicine. Scientists are harnessing the power of bacteria for **bioremediation**, using them to clean up environmental pollutants like oil spills and plastic waste. Imagine armies of specially engineered bacteria munching away at harmful substances – it's happening! In **medicine**, bacteria are being engineered to produce life-saving drugs like insulin and vaccines. Researchers are also exploring the potential of using bacteriophages (viruses that infect bacteria) to combat antibiotic-resistant infections, offering a targeted approach that spares our beneficial bacteria. The field of **synthetic biology** is allowing us to design and build new bacterial functions, opening doors to creating novel biofuels, materials, and even food sources. When we think about **lmzhBakteri** in this future context, it could represent a breakthrough strain discovered for its unique metabolic pathway, its resistance to extreme conditions, or its ability to produce a valuable compound. Perhaps 'lmzhBakteri' are the next generation of probiotics, or bacteria engineered to deliver targeted therapies directly to cancer cells. However, we can't ignore the challenges. The most pressing one is **antibiotic resistance**. As bacteria evolve, they develop defenses against our antibiotics, making infections harder to treat. This is a global health crisis that requires urgent attention, including the development of new antibiotics and responsible antibiotic use. Another challenge is understanding and managing the complex **microbiome**. While we're learning a lot, there's still so much we don't know about the intricate interactions within these microbial communities and how they impact our health and the environment. Ensuring the safe and ethical use of genetically modified bacteria is also a crucial consideration as we push the boundaries of what's possible. The future definitely holds a lot of promise for our understanding and utilization of bacteria, but it requires careful research, responsible innovation, and a global commitment to addressing the challenges they present. It's a dynamic field, and keeping up with the latest discoveries is a wild ride!
### lmzhBakteri in Research and Development
Let's zoom in a bit, guys, on how **lmzhBakteri** might specifically fit into the realm of **research and development**. Given that "lmzhBakteri" isn't a standard scientific name, it's highly probable that this term is an internal designation, a unique identifier for a specific bacterial isolate or strain being studied in a lab or research project. Think of it as a project code or a researcher's shorthand. In R&D, isolating and characterizing novel bacteria is a cornerstone of discovery. Researchers might discover a new bacterium with unique properties from a challenging environment – maybe deep-sea hydrothermal vents, acidic mine drainage, or even the gut of an unusual animal. This new isolate could be designated "lmzhBakteri" for easier tracking and reference within the lab. What makes such an isolate interesting? It could possess enzymes that function under extreme temperatures or pressures, making them valuable for industrial applications. It might produce novel antibiotics that can combat resistant pathogens, a critical need in modern medicine. Or perhaps it has a unique metabolic pathway that can efficiently break down persistent environmental pollutants, offering a greener solution for waste management. The process would involve extensive study: sequencing its genome to understand its genetic makeup, culturing it to study its growth requirements and characteristics, and testing its capabilities in various assays. For instance, if "lmzhBakteri" were found to degrade a specific plastic polymer more effectively than any known organism, it would become a prime candidate for industrial-scale bioremediation. If it exhibited potent antimicrobial activity against a multi-drug resistant strain of *Staphylococcus aureus*, it would trigger intense research into its potential as a therapeutic agent. The journey from a unique bacterial isolate to a marketable product or a widely adopted technology is long and arduous, involving rigorous testing, safety evaluations, and often, genetic modification to optimize its performance. However, the potential rewards – new medicines, cleaner environments, innovative industrial processes – make this **research and development** effort absolutely vital. So, "lmzhBakteri," whatever its specific story, likely represents a piece of this ongoing quest to unlock the secrets and harness the power of the microbial world for human benefit and planetary health.
## Conclusion: The Enduring Significance of Bacteria
So, as we wrap things up, guys, it's clear that the **enduring significance of bacteria** cannot be overstated. Whether we're talking about the general bacterial world or a specific designation like **lmzhBakteri**, these tiny organisms are fundamental to life on Earth. They are the unseen engineers of our planet, driving essential ecological processes like nutrient cycling and decomposition. They are our microscopic partners in health, forming vital communities within our bodies that aid digestion, synthesize vitamins, and shape our immune systems. And they are increasingly becoming the focus of groundbreaking innovation, offering solutions for environmental cleanup, novel medicines, and sustainable biotechnologies. While the term "lmzhBakteri" might be specific to a particular context, it serves as a reminder of the incredible diversity and potential hidden within the bacterial kingdom. Each new discovery, each new strain identified and studied, brings us closer to understanding the full scope of their impact and unlocking new ways to benefit from their abilities. The challenges, particularly antibiotic resistance, are real and require our collective effort and innovation. But the potential for bacteria to help us solve some of the world's biggest problems is immense. From maintaining the health of our planet to improving human well-being, bacteria are, and will continue to be, central to our existence. Keep exploring, keep learning, and remember the amazing world of microbes working tirelessly all around us!